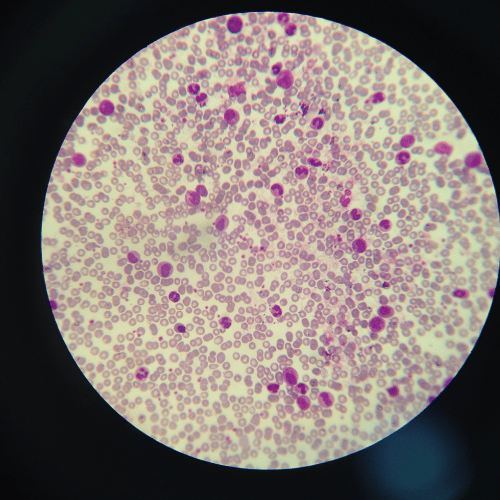
A krónikus limfoid leukémia nem jelent halálos ítéletet - Trombózis- és Hematológiai Központ

A krónikus limfoid leukémia nem jelent halálos ítéletet
A krónikus limfoid leukémia a leggyakoribb vérképzőszervi rosszindulatú betegség, mely általában idősebb korban alakul ki. A kór lefolyása rendkívül heterogén, de az esetek többségében akár évtizedes túlélést is biztosít a betegeknek. Dr. Halm Gabriella, belgyógyász, hematológust, a Trombózis- és Hematológiai Központ orvosát kérdeztük a fehérvérűség egyik altípusáról, a krónikus limfoid leukémiáról.
A krónikus limfoid leukémia
-A krónikus limfoid leukémia a nyirokrendszer betegsége, a leukémia legelterjedtebb fajtája, jellemzően 50-60 éves kor fölött alakul ki és általában több férfit érint, mint nőt. Kialakulásának okai egyelőre még tisztázatlanok, de egy többlépcsős folyamat eredményeképp jön létre, amelyhez a belső, endogén hajlam és külső környezeti ártalmak egyaránt szükségesek, és családi halmozódás is megfigyelhető – mondja dr. Halm Gabriella.
A krónikus limfoid leukémia kialakulása
-A leukémiák a fehérvérsejtek daganatos megbetegedései, amelyek a sejtek vérben való felszaporodásával járnak. Krónikus limfoid leukémia (CLL) esetén a limfociták, közülük is az ún. B limfociták szaporodnak el kóros mértékben. A B limfociták a csontvelőben és a nyirok szervekben termelődnek, és az ellenanyag-termeléssel járó, úgynevezett humorális immunválasz kialakulásában játszanak fontos szerepet. Ez azt jelenti, hogy ha kórokozókat észlelnek, akkor aktiválódnak, megjelölik a felismert kórokozót, hogy a többi immunsejt elpusztíthassa azt – magyarázza a doktornő. Ha valakinél krónikus limfoid leukémia jön létre, ezek a sejtek nem képesek ellátni normális funkciójukat. A nyiroksejtek korlátlan mértékben szaporodni kezdenek, és a vérben „felgyűlnek”. Tulajdonképpen a sejtszám növekedésben a sejtek hosszabb élettartama a felelős. Az elszaporodó sejtek beszűrik a csontvelőt és az egészséges vérsejteket kiszorítva akadályozzák a normális vérképzést, illetve a nyirokszervekben (lép, máj) is megjelennek, azok megnagyobbodását okozva.
Ezekre a tünetekre érdemes odafigyelni
-A páciensek jelentős része tünetmentes, a betegségükre gyakran egy rutin vagy egyéb okból végzett laborvizsgálatok során, az emelkedett fehérvérsejt szám alapján derül fény. Jellegzetes tünet a fájdalmatlan nyirokcsomók tapintása, főként a nyaki, hónalji régióban és a lépmegnagyobbodás, ami a bal oldali bordák alatt okozhat nyomási panaszokat az érintetteknek. A betegek sokszor a CLL szövődményei, a vérszegénység, vérlemezkehiány, visszatérő fertőzések miatt kerülnek orvoshoz – ismerteti a doktornő. Előrehaladott állapotban a nagyon erős izzadékonyság és fogyás, fáradékonyság, illetve látszólag ok nélkül jelentkező hőemelkedés és láz figyelhető meg, ezek azonban atipikus tünetek. Ismert jelenség a rovarcsípésre vagy az oltásra adott heves reakció (fájdalmas, kiterjedt bőrpír) is.
A diagnózis felállítása
-A betegségre elsősorban a magasabb fehérvérsejtszám (ezen belül is a limfocitaszám) hívja fel a figyelmet. A CLL diagnózisához legalább 3 hónapig tartó több mint 5×109 /l CLL-fenotípusú limfocita jelenlétét szükséges igazolni a perifériás vérben az ún. áramlási citometria segítségével. Ez a vizsgálat a vérben vagy csontvelőben lévő sejtek típusainak és arányainak vizsgálatát teszi lehetővé a sejtfelszínen található jellemzőik alapján. A rutin laborvizsgálatok mellett prognosztikus markerként kromoszóma és egyéb speciális molekuláris vizsgálatok is végezhetők, ezekből is kiderül, milyen betegség lefolyásra számíthatunk, mennyire kezelhető a betegség; emellett képalkotó vizsgálatok (UH, mellkas-has-kismedence CT) és csontvelő biopszia is szóba jöhetnek – részletezi a doktornő.
A krónikus limfoid leukémia kórlefolyása és kezelése
-A betegség jelenleg – ritka kivétellel – nem gyógyítható és sokféle kórlefolyású lehet. A prognózist a klinikai stádium, az életkor, a kísérőbetegségek, valamint bizonyos laboratóriumi paraméterek is befolyásolják, ezek alapján a betegek túlélése néhány hónaptól akár több évtized is lehet – ismerteti dr. Halm Gabriella, és hozzáteszi, hogy a klinikai stádium meghatározására a Rai- és a Binet-féle osztályozást használják a szakemberek. Ez klasszifikáció a lép-, máj- és nyirokcsomó megnagyobbodást, illetve a vérképeltéréseket veszi figyelembe. A CLL az esetek nagyobb részében lassú lefolyású, a kezdeti stádiumban csak vérképeltéréseket okoz, ilyen esetben elegendő a rendszeres kontroll vizsgálat is – mondja a szakember, a komolyabb tünetek (vérszegénység, trombocitaszám csökkenés, tumortömeg okozta panaszok (nyirokcsomó-, lépnagyobbodás, immuncitopéniák) megjelenésével azonban szükségessé válik a kezelés. A krónikus limfoid leukémia kezelése sokat változott az elmúlt években. Korábban kiemelt szerepe volt az immunkemoterápiának. Jelenleg a kemoterápia háttérbe került, és az immunoterápiával kombinált jelátviteli útvonalakat speciálisan gátló gyógyszeres kezelések kerültek előtérbe. Utóbbiak segítségével lehetővé válhat, akár évekig tartó kezelésmentes időszak is. A kezelések általában nem terhelik meg a betegeket. Nem igényelnek hosszas kórházi bentfekvést és jól tolerálhatóak.
A betegség jelenleg egyetlen gyógymódja azonban, ami végleges gyógyulást hozhat, a csontvelőtranszplantáció, ami csak jó általános állapotú, fiatal betegeknél jöhet szóba, mert rendkívül kockázatos, a beavatkozás szükségességéről pedig egy bizottság dönt.
-Fontos hangsúlyozni, hogy bár a leukémia kifejezést hallva sokan azonnal a lehető legrosszabbra gondolnak, a gondos kezelés mellett a krónikus limfoid leukémia, a ma elérhető modern terápiás módszereknek köszönhetően az esetek nagy részében nem rontja jelentősen az érintettek életkilátásait – nyugtat meg mindenkit dr. Halm Gabriella, Trombózis- és Hematológiai Központ belgyógyász, hematológus orvosa.
Foglaljon időpontot orvosainkhoz!
Téma szakértője
Dr. Halm Gabriella
belgyógyász, hematológus
- Specialitások:
- fehérvérsejt eltérései
- alacsony trombocitaszám
- alacsony/magas hemoglobin szint
- egyéb vérképeltérések tisztázása
- kizárólag felnőtt ellátás (18 éves kor felett)
- Rendelés típusa:
- személyes (rendelői) konzultáció
Kapcsolódó oldalak
Páciensek mondták
Alapos és precíz
A Főorvosnő igen nagy tudással rendelkező orvos! Rendkívül alaposan és precízen nézte át a leleteimet és vizsgált meg. Mindezek mellett a hozzáállása is betegközpontú!